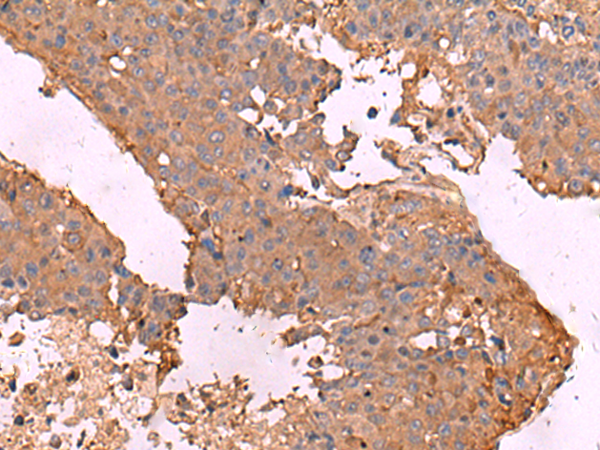

别名:应用:WB,IHC
反应种属:Human
规格:50μl/100μl
| Description |
|---|
| This gene encodes a protein that is a member of the integrin superfamily. Members of this family are adhesion receptors that function in signaling from the extracellular matrix to the cell. Integrins are heterodimeric integral membrane proteins composed of an alpha chain and a beta chain. The encoded protein forms dimers with an alpha4 chain or an alphaE chain and plays a role in leukocyte adhesion. Dimerization with alpha4 forms a homing receptor for migration of lymphocytes to the intestinal mucosa and Peyer’s patches. Dimerization with alphaE permits binding to the ligand epithelial cadherin, a calcium-dependent adhesion molecule. Alternate splicing results in multiple transcript variants. Additional alternatively spliced transcript variants of this gene have been described, but their full-length nature is not known. |
| Specification | |
|---|---|
| Swissprot | P26010 |
| WB Predicted band size | 87 kDa |
| Host/Isotype | Rabbit IgG |
| Storage | Store at 4°C short term. Aliquot and store at -20°C long term. Avoid freeze/thaw cycles. |
| Species Reactivity | Human |
| Immunogen | Synthetic peptide of human ITGB7 |
| Formulation | pH7.4 PBS, 0.05% NaN3, 40% Glycerol |
| Application | |
|---|---|
| WB | 1/500-1/2000 |
| IHC | 1/50-1/300 |
| ELISA | 1/5000-1/10000 |
![]() |
Gel: 6%SDS-PAGE, Lysate: 40 μg, Lane 1-2: 231 and A172 cell lysates, Primary antibody: P04975(ITGB7 Antibody) at dilution 1/900, Secondary antibody: Goat anti rabbit IgG at 1/5000 dilution, Exposure time: 5 minutes |
![]() |
The image is immunohistochemistry of paraffin-embedded Human liver cancer tissue using P04975(ITGB7 Antibody) at dilution 1/40. (Original magnification: ×200) |
![]() |
The image is immunohistochemistry of paraffin-embedded Human colorectal cancer tissue using P04975(ITGB7 Antibody) at dilution 1/40. (Original magnification: ×200) |
本公司的所有产品仅用于科学研究或者工业应用等非医疗目的,不可用于人类或动物的临床诊断或治疗,非药用,非食用。
暂无评论
本公司的所有产品仅用于科学研究或者工业应用等非医疗目的,不可用于人类或动物的临床诊断或治疗,非药用,非食用。
中文

发表回复